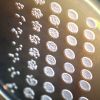
Nature (Великобритания): опасности редактирования генома человека (Культуры дрожжей с пересаженными человеческими генами | © Rainis Venta) Культуры дрожжей с п…

|
|
 К началу весеннего контрнаступления сил ПНС Ливии и Турции на войска Хафтара ЛНА продолжала попытки продвижения в южных кварталах Триполи, но без успеха. О взятии Триполи уже не было и речи, несмотря на то, что командование ЛНА 3 или 4 раза объявляло о «последнем и решительном» наступлении на город. Желания здесь явно не совпали с возможностями. Помощь спонсоров Хафтара также оказалась недостаточной, а ПНС Ливии получило военную поддержку Турции.
|
|
|
|
|
|
 Поскольку у нас сейчас идёт первый курс карьерного консалтинга и уже объявлен второй, со стороны наших слушателей как уже состоявшихся, так и потенциальных, появляется очень много вопросов. И становится понятно, что в «Лестнице в небо» на многие из них ответов нет. Кое-какие и не должны там быть, поскольку они слишком утилитарные, но некоторые реально являются принципиальными. И поэтому начну я с конкретного примера.
|
|
|
|
|
|
 "Профиль" познакомил нас с весьма интересной позицией Тимофея Бородачёва, программного директора Валдайского клуба. Понятно, что рано или поздно позиция наших специфических элитариев должна была выйти в публичное пространство, но вряд ли можно было ожидать, что так наглядно, быстро и жёстко. Очевидно, что коронавирус (КВ) — это одно, а заметная элитаризация мира и переход к положению супергосподства меньшинства и суперподчинённости...
|
|
|
|
|
 Польша уже успела стать важным инструментом, который активно используют США в противостоянии с Россией, отмечает китайский интернет-пользователь. Вот и теперь Штаты с ее помощью провоцируют Россию. Но Польше придется заплатить высокую цену за такое проамериканское поведение, уверен автор. Польша была одной из участниц Организации Варшавского договора при ведущей роли бывшего СССР, и после распада ОВД она начала действовать опрометчиво,..
|
|
|
|
|
|
 С цифрами наперевес Западная Европа, кажется, уже замерла на низком старте в ожидании отмены карантина и самоизоляции. Кто-то продолжает считать убытки, пресса без пафоса и даже без возмущения обсуждает безудержный рост прибылей миллиардеров, а банки на Западе уже отчитываются о росте накоплений широкой публики. Однако ничего подобного из-за стен российских кредитных учреждений пока не слышно. Безальтернативный лидер банковского сектора,..
|
|
|
|
|
|
 Та скорость, с которой за последние дни пронеслось множество знаковых для Украины событий, меня удивила. Как и масштаб этих самых событий. Пресловутое колесо генотьбы многократно набрало обороты, круша и давя все розовые «мрии» украинского политического класса и украинских граждан, которые в «зеленом» порыве год назад избрали на пост главы государства молодого и креативного гражданина, незадолго до этого сыгравшего роль президента в комедийном сериале. Честно говоря, я не ожидал...
|
|
|
|
|
 Уволенный Владимиром Путиным глава Чувашии Михаил Игнатьев подал на президента в суд — Верховный суд принял его заявление об административном иске об оспаривании указа главы государства о досрочном прекращении полномочий руководителя региона в связи с утратой доверия. Игнатьев был уволен в конце января — после некрасивой истории на церемонии в региональном управлении МЧС: тогда он заставил офицера подпрыгнуть за ключами от новой...
|
|
|
|
|
|
 Россия обошла Саудовскую Аравию, став крупнейшим поставщиком нефти в Китай в апреле 2020 года, свидетельствуют данные Главного таможенного управления Китая. Однако аналитики считают, что потерянная Саудовской Аравией и полученная Россией доля рынка — это лишь временное явление. Россия в прошлом месяце стала крупнейшим поставщиком сырой нефти в Китай, и теперь объем ее поставок...
|
|
|
|
|
|
 Для Донбасса пошёл седьмой год войны, в это трудно поверить, но всё так же рвутся снаряды, люди прячутся в подвалах, в окнах нет стёкол, а в огородах полно осколков. Обстрел Александровки произошёл как раз накануне видеоконференции, во время которой украинскую делегацию уговаривали начать согласовывать «дополнительные меры контроля действующего бессрочного перемирия». Перемирие в этом случае звучит как насмешка.
|
|
|
|
|
 Когда-то британский историк и журналист Найл Фергюсон утверждал в книге The West and the Rest, что западная культура играет в мире главенствующую роль, служит образцом для «остальных». Сомнения в подобных утверждениях существовали на Западе всегда, но «вот пришёл вирус» – и сомнения укрепились. «Запад не может больше считать себя образцом для всего мира» – под таким заголовком французская Libération поместила интервью с писателем...
|
|
|
|
|
|
 Бывшие послы США на Украине призывают к сокрытию коррупционных преступлений За последние три десятилетия Соединенные Штаты и Украина установили широкие и прочные отношения, которые служат интересам обеих стран, стран, которые разделяют такие ценности, как демократия, свобода и свобода человека. Успех Украины в развитии как независимого, стабильного, демократического государства с сильной рыночной экономикой, привязанной к европейским...
|
|
|
|
|
|
 Ни для кого не секрет, что в последнее время найти хороших специалистов, в любой сфере нашей жизни, достаточно трудно, причем это утверждение касается как товаров, так и услуг. И если с товарами повседневного спроса дела обстоят проще, потому что и выбор здесь достаточно широкий и сталкивается с этим выбором товаров каждый человек практически ежедневно. Другое дело - юридические услуги.
|
|
|
|
|
 Слово «заговор» в обороте уже полвека. Оно используется для дискредитации тех политиков, экспертов, общественных деятелей, которые пытаются доказать, что на планете выстраивается новый мировой порядок в интересах хозяев денег – главных акционеров Федеральной резервной системы США: мол, всё развивается само собой и никакого заговора, никакого тайного плана переустройства мира нет. Я уже писал, что выражения «теория заговора»,..
|
|
|
|
|
|
 В кампаниях с 2004 по 2009 г. ПР и лично Янукович обещали предоставить русскому языку статус второго государственного. Отрёкся «пророссийский президент» от своих слов через неделю после инаугурации. В первый же год правления лидера ПР из предвыборной программы кандидата в президенты Виктора Януковича исчез с официального сайта партии раздел «Два языка – одна страна!». Исчезло положение...
|
|
|
|
|
|
 Владимир Путин провел видеоконференцию с мэром Москвы Сергеем Собяниным, на которой градоначальник доложил президенту об успехах и планах по дальнейшему регулированию жизни москвичей. Из главного, о чём можно было узнать из доклада мэра, стоит отметить, что в Москве заработали все стройки, а следовательно, и увеличился пассажиропоток, в связи с чем власти вновь вынуждены были ужесточить санитарные требования к работодателям и...
|
|
|
|
|
 Вчера Президент Российской Федерации Владимир Путин в беседе с министром обороны Сергеем Шойгу дал указание провести парад в честь 75-летия Победы 24 июня. Ровно через 75 лет после исторического парада, который также был не 9 мая, а 24 июня. И это понятно, потому что тогда нужно было время на подготовку к такому торжественному мероприятию. И не нужно забывать, что после смерти Гитлера его преемник Карл Денниц ещё некоторое время...
|
|
|
|
|
|
 Сегодня практически уже никто в Украине не спорит о важности местных выборов, назначенных на 25 октября сего года. Потому что они станут лакмусовой бумажкой, показателем, с одной стороны, степени дезинтеграции странны и доверия местных элит центральной власти. Это уже давняя украинская традиция – как только центр начинает слабеть и диктует дурацкую или вообще невнятную политику, обдирая при этом регионы материально, так сразу...
|
|
|
|
|
|
 Ещё в бытность президентом Украины Петра Алексеевича Порошенко я придумал термин «негативная рекоммунизация» – это когда мы на словах проклинаем советское прошлое, а на деле воспроизводим «прошедшего житья подлейшие черты». Причём не обязательно даже реальные – пойдут и выдуманные антикоммунистической пропагандой. Казалось бы, ситуация на Украине после победы Владимира Зеленского изменилась. Но – ничего подобного. Прошёл год...
|
|
|
|
|
 Информационная повестка последних недель переходит в "белый шум", где скандалы и выходки отдельных персон начинают подменять собой реальную политику и жизнь. Уволенный в январе глава Чувашии подготовил иск… к президенту Владимиру Путину. Событие само по себе настолько же скандальное, насколько и беспрецедентное, экс-руководитель оказался недоволен формулировкой "в связи с утратой доверия", которая для отставки губернаторов и глав субъектов...
|
|
|
|
|
|
 Уникальная структура COVID-19 заставляет предположить, что он либо был создан человеком либо является природной «полной случайностью». С такой версией выступил ведущий австралийский ученый, специализирующийся на вакцинах. Коронавирус настолько «идеально приспособлен» для заражения людей, что нельзя игнорировать возможность его происхождения из лаборатории, считают австралийские...
|
|
|
|
|
|
 Нерабочие дни заканчиваются, пора на работу. Инструкция для работодателей по выходу из карантина. 31 мая 2020 года для многих регионов России может завершиться режим самоизоляции и вероятно возобновление нормального графика работы. Например, в Тюменской области приостановка выхода из режима самоизоляции и режима повышенной готовности ориентирует граждан на 31 мая, но с учетом эпидемической ситуации. Фактически регионы уже...
|
|
|
|
|
 В то время как Россия, по образному выражению Александра Михайловича Горчакова, последнего канцлера Российской империи и главы российского внешнеполитического ведомства при императоре Александре II, все больше «сосредотачивается», в ряде постсоветских республик назревают панические и даже истерические настроения среди представителей местных элит. По ночам их мучает призрак Януковича. Редкий случай, когда призрак вдруг появляется при еще живом «хозяине».
|
|
|
|
|
|
 Видимый парадокс заключается в том, что «сепаратистская держава» должна стремиться отделиться от чего-то целого. В то же время «глобальные амбиции» предполагают не просто интеграцию в нечто большее, чем собственное государство, но даже выдающуюся роль в создании этого общего — глобального, всемирного, общечеловеческого. Основные признаки украинского сепаратизма, мешающие киевским властям даже с восточноевропейскими членами...
|
|
|
|
|
|
 В жизни любого человека порой случаются ситуации, когда возникает потребность срочно раздобыть деньги. Причем, речь зачастую идет о довольно серьезной сумме. Легковой автомобиль - это актив, который при желании (и при острой необходимости) всегда можно конвертировать в денежные знаки. Сегодня мы расскажем о том, какая компания осуществляет срочный выкуп авто любой марки и с любым пробегом на самых выгодных для клиентов условиях. Срочный выкуп авто за 1 час.
|
|
|
|
|
 Как коронавирус сделал американских толстосумов еще богаче. Вот уж действительно: кому война, а кому – мать родна. Так и с войной против пандемии коронавируса: кто заболел, кто умер, кто обнищал, а вот американские толстосумы сейчас довольно потирают руки. Как сообщил американский портал inequality.org Института политических исследований, миллиардеры США на пандемии баснословно нажились. Совокупное состояние американских миллиардеров увеличилось на...
|
|
|
|
|
|
 Во вторник, 26 мая, пятый президент Украины Петр Порошенко открыл выставку картин в музее Ивана Гончара в центре Киева. - Сегодня в музее Ивана Гончара открывается выставка художественных работ из коллекции Петра и Марины Порошенко. После завершения карантина десятки тысяч поклонников искусства смогут ознакомиться с лучшими образцами мирового искусства из нашей коллекции, которую мы бережно собирали. Это было задолго до войны,...
|
|
|
|
|
|
 Речь идет о личности 35-летнего начальника сектора Николая Кузива. Он родом из Львовской области. Одна существенная деталь его биографии заставляет всмотреться в него куда пристальней. Насильник является ветераном АТО. О Кузиве есть упоминание на сайте мариупольской полиции, хотя, по всей вероятности, скоро оно оттуда исчезнет. Там говорится, что он участвовал в военных действиях на Донбассе, после чего устроился работать полицейским.
|
|
|
|
|
 Сергей Собянин подписал указ о продлении самоизоляции, пропускного режима и остальных ограничительных мер до 14 июня 2020 года. "Ещё рано открывать театры, музеи, парикмахерские, рестораны и фитнес-клубы", – объявил ССС. Масочно-перчаточный режим будет доведён до абсурда (маски необходимо одевать сразу, выходя из дома). Сидеть на лавочках и играть на детских площадках по-прежнему нельзя. Одновременно власти...
|
|
|
|
|
|
 «Отец-основатель украинской нации» (определение дано вице-президентом США Джо Байденом, «плёнки Деркача», фрагмент 02, 1 мин. 42 сек.) бежал огородами от следователей Государственного бюро расследований, придерживая полы плаща в районе вспотевших гениталий. Бежать пришлось метров сто, однако для организма гаранта, измученного детоксом и стрессами, это было серьёзное испытание. Он уже далеко не мальчик, чтобы вот так бегать...
|
|
|
|
|
|
Получается, что американские интересы – приоритет украинской политики. Так было при Порошенко, так остаётся и при Зеленском. И Минске договорённости нужны Киеву только для того, чтобы удерживать европейцев от снятия санкций. Определённые круги в США руками националистов и дальше будут раскачивать ситуацию на Украине. А президенту Зеленскому не стоит пытаться им понравиться – ему надо наконец прислушаться к мнению граждан.
|
|
|
|
|
| |
|
|